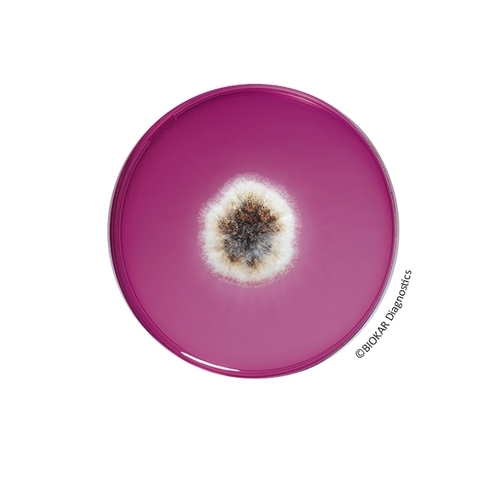
Dichloran Rose Bengal Chloramphenicol (DRBC) Agar

Dichloran Rose Bengal Chloramphenicol (DRBC) Agar
Dichloran Rose Bengal Chloramphenicol agar is recommended for the enumeration of viable yeasts and molds that develop in products destined for human and animal consumption with a water activity (aw) greater than 0.95. The media does not allow for the enumeration of mold spores.
| Ürün Adı | Dichloran Rose Bengal Chloramphenicol (DRBC) Agar |
| Ürün Kodu | BM14208 |
| Miktar | 10 vials of 200 mL |
| Ürün Adı | Dichloran Rose Bengal Chloramphenicol (DRBC) Agar |
| Ürün Kodu | BK198HA |
| Miktar | 500 g |